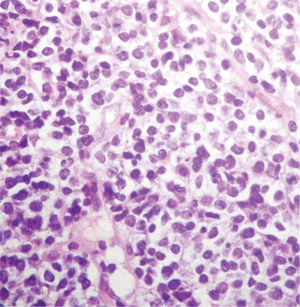
Linfoma B de grado bajo (linfoma de la zona marginal). Los linfocitos son de tamaño mediano, de contornos redondeados a irregulares, e invaden el epitelio glandular en pequeños nidos. Tinción HE 40×.

Los linfomas primarios de mama (LPM) constituyen una entidad clínica muy poco frecuente; representan menos del 1% de los tumores malignos de mama.
Debido a su baja frecuencia es rara su consideración en la evaluación preoperatoria de pacientes que presentan un tumor mamario. Habitualmente no presenta signos clínicos ni mamográficos que nos hagan pensar en esa entidad.
El diagnóstico es fundamentalmente anatomopatológico y para su inclusión como linfoma primario de mama debe hacerse un exhaustivo estudio de extensión y cumplirse los criterios originalmente descritos por Wiseman y Liao. El manejo inicial es quirúrgico con fines diagnósticos, pues la extensión de la cirugía no influye en el control local de la enfermedad. El tratamiento de elección es radioterápico, con o sin quimioterapia asociada, según el fenotipo histológico del tumor.
Como único factor pronóstico estadísticamente significativo se considera la estadificación de Ann-Arbor.
Tomando como referencia la base de datos de la unidad de mama del Hospital 12 de Octubre, describimos 3 casos clínicos de linfomas primarios de mama diagnosticados entre los años 1990 y 2005, y realizamos una amplia revisión bibliográfica del tema.
Less than 1% of all malignant breast tumors are due to primary lymphoma.
Because the frequency of this type of tumor is low, primary lymphoma is often overlooked in the preoperative evaluation of patients with breast tumors. Furthermore, there are no specific radiological or clinical findings that would suggest this entity.
Diagnosis is based on histopathology. Before a diagnosis of primary breast lymphoma can be made, extensive investigations must be performed to ascertain that the criteria defined by Wisemand and Liao are fulfilled.
The treatment strategy is surgical for diagnostic purposes but the extent of the surgery does not influence local control of the disease. The treatment of choice is radiation therapy with or without chemotherapy, depending on the tumoral phenotype.
The only statistically significant prognostic factor in this entity is the Ann-Arbor staging system. Using the 12 de Octubre Hospital’s database as reference, we describe three cases of primary breast lymphoma diagnosed between 1990 and 2005. A comprehensive review of the literature is also provided.
Se define los linfomas como neoplasias del sistema linfoide que asientan preferentemente en los ganglios linfáticos u otros tejidos linfoides. Podemos diferenciar dentro de ellos 2 grupos bien establecidos1: linfomas tipo Hodgkin (LH) y tipo no Hodgkin (LNH).
Son fundamentalmente los LNH los que producirán afectación extraganglionar con más frecuencia. Pueden involucrar diferentes tejidos linfoides situados en diferentes localizaciones, como la mama o el útero; por tanto, en este artículo nos referiremos a éstos.
La mayoría de los LNH se originan de las células B2,3. Cuando la afectación del LNH es mamaria, podemos diferenciar 3 grupos4: a) linfoma primario de mama (LPM); b) linfoma sistémico con afectación mamaria, y c) recidiva de linfoma previo en la mama.
Los LPM constituyen una entidad clínica muy poco frecuente; representan menos del 1% de los tumores malignos de mama y aproximadamente entre el 2-3% de los linfomas extranodales5. La primera referencia bibliográfica del tema es de Kundrar, en 18936.
Debido a su baja frecuencia, es rara su consideración en la evaluación preoperatoria de pacientes que presentan un tumor mamario, sobre todo porque no asocian signos clínicos ni mamográficos específicos (fig. 1) que nos hagan pensar en esta entidad7.
El diagnóstico se basa fundamentalmente en los hallazgos anatomopatológicos8 (figs. 2-4) y exige un exhaustivo estudio de extensión. Los criterios de Wiseman y Liao (tabla 1) definen el carácter primario del linfoma de mama (frente a afectación secundaria)9.
Criterios de Wiseman y Liao
|
El manejo inicial suele ser quirúrgico, con fines diagnósticos, ya que la extensión de la cirugía no parece influir en el control local de la enfermedad. El tratamiento de elección es sistémico (quimioterapia o radioterapia)10,11.
A diferencia de los linfomas diseminados, los de localización primaria mamaria presentan con mayor frecuencia grados de diferenciación intermedio o alto, circunstancia que condiciona la necesidad de tratamiento quimioterápico4.
Según las diferentes series revisadas, la estadificación de Ann-Arbor (tabla 2) representa el único factor pronóstico estadísticamente significativo4,10–12.
Estadificación de Ann-Arbor
| Estadio I: afectación de una única región ganglionar o una única afectación extralinfática |
| Estadio II: afectación de 2 o más regiones ganglionares al mismo lado del diafragma |
| Estadio IIE: afectación de una o más regiones a un lado del diafragma y de un territorio extralinfático |
| Estadio III: afectación de regiones ganglionares o localizaciones extralinfáticas a ambos lados del diafragma |
| Estadio IV: afectación diseminada extralinfática de uno o más órganos extralinfáticos, son o sin afectación ganglionar Subestadio A: pacientes sin síntomas B Subestadio B: pacientes con síntomas B |
| Síntomas B: fiebre, sudoración nocturna y pérdida de peso superior al 10%. |
Realizamos una presentación de 3 casos de LPM diagnosticados y tratados en nuestro centro entre los años 1990 y 2005.
Evaluamos las características clínicas y radiológicas, el tratamiento, los factores pronósticos y la evolución de estas pacientes. Todos los casos cumplían los criterios diagnósticos de Wiseman y Liao (tabla 1).
Caso 1Paciente mujer, de 57 años, tercípara, lactancia materna, sin hábitos tóxicos de interés. Entre sus antecedentes personales destacaba cardiopatía en tratamiento (doble lesión aórtica).
Acudió a nuestra consulta refiriendo la autopalpación de una tumoración de 1cm localizada en el cuadrante inferoexterno de la mama izquierda. No presentaba ninguna otra clínica concomitante.
A la exploración se confirmó la existencia de ese nódulo de consistencia dura, que no presentaba adherencia a planos; la exploración axilar fue negativa.
En la mamografía se evidenció la presencia de un nódulo con bordes parcialmente definidos, que ecográficamente correspondía a una imagen solonuscente, tabicada; se realizó una punción que el análisis histológico informó de atipias citológicas.
Se programó una biopsia intraoperatoria. La anatomía patológica informaba de carcinoma ductal infiltrante; se completó la cirugía con tumorectomía y linfadenectomía axilar.
El resultado de anatomía patológica fue proceso linfoproliferativo altamente sospechoso de linfoma difuso de células B de bajo grado, con 18 ganglios negativos.
De acuerdo con este resultado, se completó el estudio de extensión; no se evidenció afectación en otras áreas linfoides y se tipificó en estadio I de Ann-Arbor.
La paciente fue remitida a radioterapia y recibió radioterapia local.
La última revisión fue en mayo 2005; el linfoma estaba en remisión.
Caso 2Paciente mujer, de 62 años, tercípara, lactancia materna, sin hábitos tóxicos ni antecedentes personales de interés.
Acudió a nuestra consulta refiriendo la autopalpación de una tumoración de 6cm localizada en el cuadrante superointerno de la mama izquierda. No presentaba ninguna otra clínica concomitante.
A la exploración se confirmó la presencia de un nódulo de consistencia dura, que no presentaba adherencia a planos profundos; en la axila presentaba adenopatías móviles homolaterales.
El estudio mamográfico evidenció la presencia de una masa de 7 por 8cm, con bordes bien definidos, sugestiva de malignidad.
Ante los hallazgos clínicos y mamográficos, se realizó una punción con aguja gruesa, con resultado de linfoma difuso de células B.
Los análisis preoperatorios fueron normales. Se realizó una excisión parcial de 2cm para confirmar el diagnóstico.
El resultado del análisis de anatomía patológica fue de linfoma difuso de células B, de grado intermedio.
El estudio de extensión no mostró afectación en otras áreas linfoides, y se tipificó en estadio IIE de Ann-Arbor.
Se remitió a la paciente a oncología, donde recibió tratamiento combinado de quimioterapia con 6 ciclos de CHOP (ciclofosfamida, vincristina, adriamicina, prednisona) y radioterapia local.
Tras 2 años del diagnóstico inicial, se evidenciaron metástasis cervicales, en el paladar y la nasofaringe. Fue tratada con quimioterapia según el esquema MINE (ifosfamida, mitoxantrona, etopósido), 4 ciclos y 3 ciclos de hiper-CVAD (ciclofosfamida, adriamicina, vincristina y dexametasona) y, posteriormente, monoterapia con VP-16 (etopósido). El linfoma fue refractario al tratamiento. La paciente falleció 3 años después del diagnóstico inicial por insuficiencia respiratoria.
Caso 3Paciente mujer, de 61 años, secundípara, lactancia materna, sin hábitos tóxicos ni antecedentes de interés, que consultó por una tumoración localizada de 5cm en los intercuadrantes inferiores de la mama izquierda. No presentaba ninguna otra clínica concomitante.
A la exploración se palpó un nódulo de consistencia dura, que no presentaba adherencia a planos; la exploración axilar fue negativa.
La mamografía informaba de la presencia de un foco de hiperdensidad mamaria, mal delimitado; se recomendó su exéresis.
El resultado de la anatomía patológica fue linfoma difuso de células B, de grado intermedio.
El estudio de extensión no mostró afectación de otras áreas linfoides. El linfoma correspondía al estadio I de Ann-Arbor.
Se remitió a la paciente al servicio de oncología, donde recibió tratamiento combinado de radioterapia local y quimioterapia, con 6 ciclos de CHOP, 1 ciclo de DHAP (arabinósido citosina, cisplatino y prednisona) y, por toxicidad a este último, se inició un esquema VP-16 con buena respuesta.
La última revisión fue en mayo 2005; el linfoma estaba en remisión.
DISCUSIONEl LPM según las diferentes series revisadas, así como en la nuestra propia, es más prevalente en edades medias. Presenta un pico de incidencia en la sexta década de vida13,14.
Suele debutar como una masa palpable, de rápido crecimiento, que no presenta los signos propios del resto de las neoplasias mamarias. Es infrecuente la presencia de telorragia, retracción de piel o de pezón y la adherencia a planos7,10,12; estos hallazgos se confirmaron en nuestra casuística. La localización más común, según la bibliografía revisada, es en los cuadrantes superoexternos. Es infrecuente la bilateralidad, salvo en mujeres gestantes7.
La evaluación inicial para su tipificación como linfoma primario incluye la práctica de10:
- 1.
Anamnesis y exploración física.
- 2.
Analítica general, con función hepática y renal.
- 3.
Biopsia de médula ósea.
- 4.
Radiografía de tórax.
- 5.
Mamografía.
- 6.
Tomografía computarizada toracoabdominopélvica.
Los hallazgos mamográficos no son específicos15,16 y varían desde la presencia de un nódulo espiculado hasta el aumento de densidad mamaria. En nuestra casuística, 2 casos presentaban una masa tumoral de bordes parcialmente definidos (fig. 1) y en uno de ellos la mamografía informó de la existencia de un foco hiperdenso mal delimitado. En el análisis radiológico, los tumores primarios presentan márgenes menos definidos y diámetros mayores que aquellos linfomas con afectación difusa16.
La extensión de la cirugía no parece tener trascendencia en el control local de la enfermedad, por lo cual existe un acuerdo entre los diferentes autores sobre la abstención de cirugía radical en estas pacientes17.
El manejo de los LPM debería basarse en el grado histológico; de esta manera, las pacientes con linfomas de bajo grado pueden tratarse con terapia local (la quimioterapia en este grupo es controvertida). Sin embargo, en las que presentan grado alto o intermedio debe llevarse a cabo, además, quimioterapia18,19.
La mayoría de los LPM son de grado alto o intermedio4, como se confirma en nuestra serie, mientras que los linfomas diseminados presentan, generalmente, un grado bajo.
En el análisis histológico, la mayoría corresponde a linfomas difusos; es menos frecuente el tipo folicular11,20. Los 3 casos clínicos correspondían a linfomas difusos de células B.
En cuanto al pronóstico, el único factor estadísticamente significativo parecer ser el estadio clínico según la clasificación de Ann-Arbor4,10–12; en las series revisadas hemos encontrado una supervivencia del 83% a los 5 años cuando se clasificaban en estadio I, mientras que los que presentaban un estadio II tenían una supervivencia del 20%. En nuestra serie, dos de ellos presentaban un estadio I por lo que, con el tratamiento pautado, se consiguió la remisión del linfoma y, por tanto, la supervivencia de las pacientes, mientras que la paciente con tumor tipificado en estadio IIE falleció a los 3 años del diagnóstico.